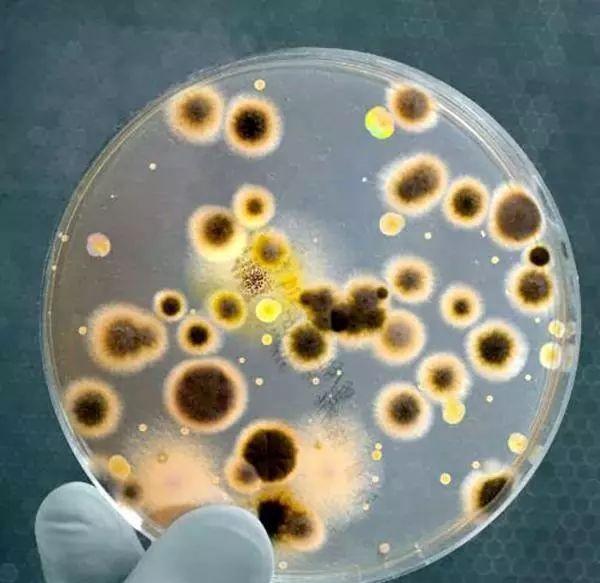
『蛋白质』人类体温为何是37℃,而不是27℃或者47℃?

『蛋白质』人类体温为何是37℃,而不是27℃或者47℃?

文章图片

文章图片
人类祖先经过长时间的进化 , 把平均体温确定在37℃左右 , 主要是这个温度下能量消耗达到最优值 , 还有研究表明 , 这个温度下人类感染真菌的概率与能量消耗也达到最优 。
在某些书籍当中 , 介绍人类体温保持在37℃ , 说是因为这个温度下体内的酶活性最高 , 使得人体对能量的利用率也最高 。
这个说法本身没有错 , 但是前因后果颠倒了 , 因为酶属于蛋白质 , 不同结构的蛋白质能在不同温度下保持最高活性 , 人类偏偏选择了37℃左右这个蛋白质 , 肯定有更深层的原因 。
人在不同的年龄段 , 以及不同的身体部位体温有差异 , 比如成年人的口腔温度为36.7~37.7℃ , 直肠体温36.9~37.9℃ , 腋窝温度36.0~37.4℃ , 可以认为人的平均体温在37℃左右 。
在地球上 , 所有的哺乳动物都是恒温动物 , 恒温动物的平均体温均在38℃左右 , 所以38℃基本就是一个黄金温度 , 哺乳动物在地球生物中属于高级形式 , 但恒温动物中也有卵生动物 , 比如鸟类 , 鸟类的平均体温在41℃左右 。
恒温动物相对于变温动物来说具有很大的优势 , 尤其是恒温动物可以在任何外界温度下 , 保持较高的运动水平 , 从而能适应更复杂的环境 , 而变温动物的行动能力受环境温度的影响很大 , 在低温时还需要进行休眠 。
但是恒温动物也有着很明显的弱点 , 比如:
1、需要消耗更多的能量 , 来维持自身的体温 , 而同体积变温动物能量消耗只有恒温动物的十分之一 , 于是恒温动物需要不断地进食 。
2、在环境温度较低时容易失温 , 于是需要借助其他手段来保持体温 , 比如人类需要添加衣物 , 部分野生动物需要聚集起来取暖等等 。
对于人类来说 , 环境温度变化一定的情况下 , 平均体温的增加 , 会消耗掉更多的能量 , 如果平均体温降低 , 机体的反应速度和运动能力也会大大降低 , 于是就存在一个最佳温度 , 使得这两方面达到最优值 , 人类最终选择了37℃ 。
也有生物学家提出 , 人类平均体温的进化 , 或许与真菌有关 , 自然界中很多真菌是人类的致命杀手 , 然而真菌喜欢低温 , 超过三分之二的真菌在37℃以上无法生存 , 人类能接触到的真菌高达4000种 , 但是只有400多种能引起感染 , 其中一个原因就是体温 。 相比之下 , 鸟类拥有更高的平均体温 , 于是鸟类感染真菌的可能性更低 。
但是人类不能随便提高体温 , 因为那样会消耗更多的能量 , 生物学家经过计算 , 避免真菌感染和降低体能消耗的最优解 , 是体温保持在36.7℃左右 , 与人类体温基本吻合 。
【『蛋白质』人类体温为何是37℃,而不是27℃或者47℃?】来源: 未知科学
- 『乐居网』亚马逊下周将为仓储员工配备口罩和体温检测设备
- 「大千新鲜事」地球竟有2颗卫星?另一颗卫星去哪了?
- 【硅谷密探】机器人会比人类更有人性吗?,《西部世界》第三季开播
- 「智东西」FCA旗下员工减薪20% 明年3月偿还,智东西晚报:DeepMind在57款雅达利游戏超人类玩家
- 『快科普』有什么后果?科学家:身体会垮掉,如果人类的大脑开发到100%
- [木易机械]那位女机器人,现在怎么样了?,曾经放狠话要“毁灭人类”
- 欢乐聊奇闻故事@他发现了什么?真相让人害怕,霍金多次告诫人类要尽快离开地球
- 兽语十级:兽语十级 华为成功研制“动物语言翻译机”
- 冰阳杂谈■想不到人类被一个花花公子救了:五分钟看完《三体》第二部
- 「虫洞科技」科学家: 这就是人类一直要找的!,从64亿公里外传回清晰照片,
